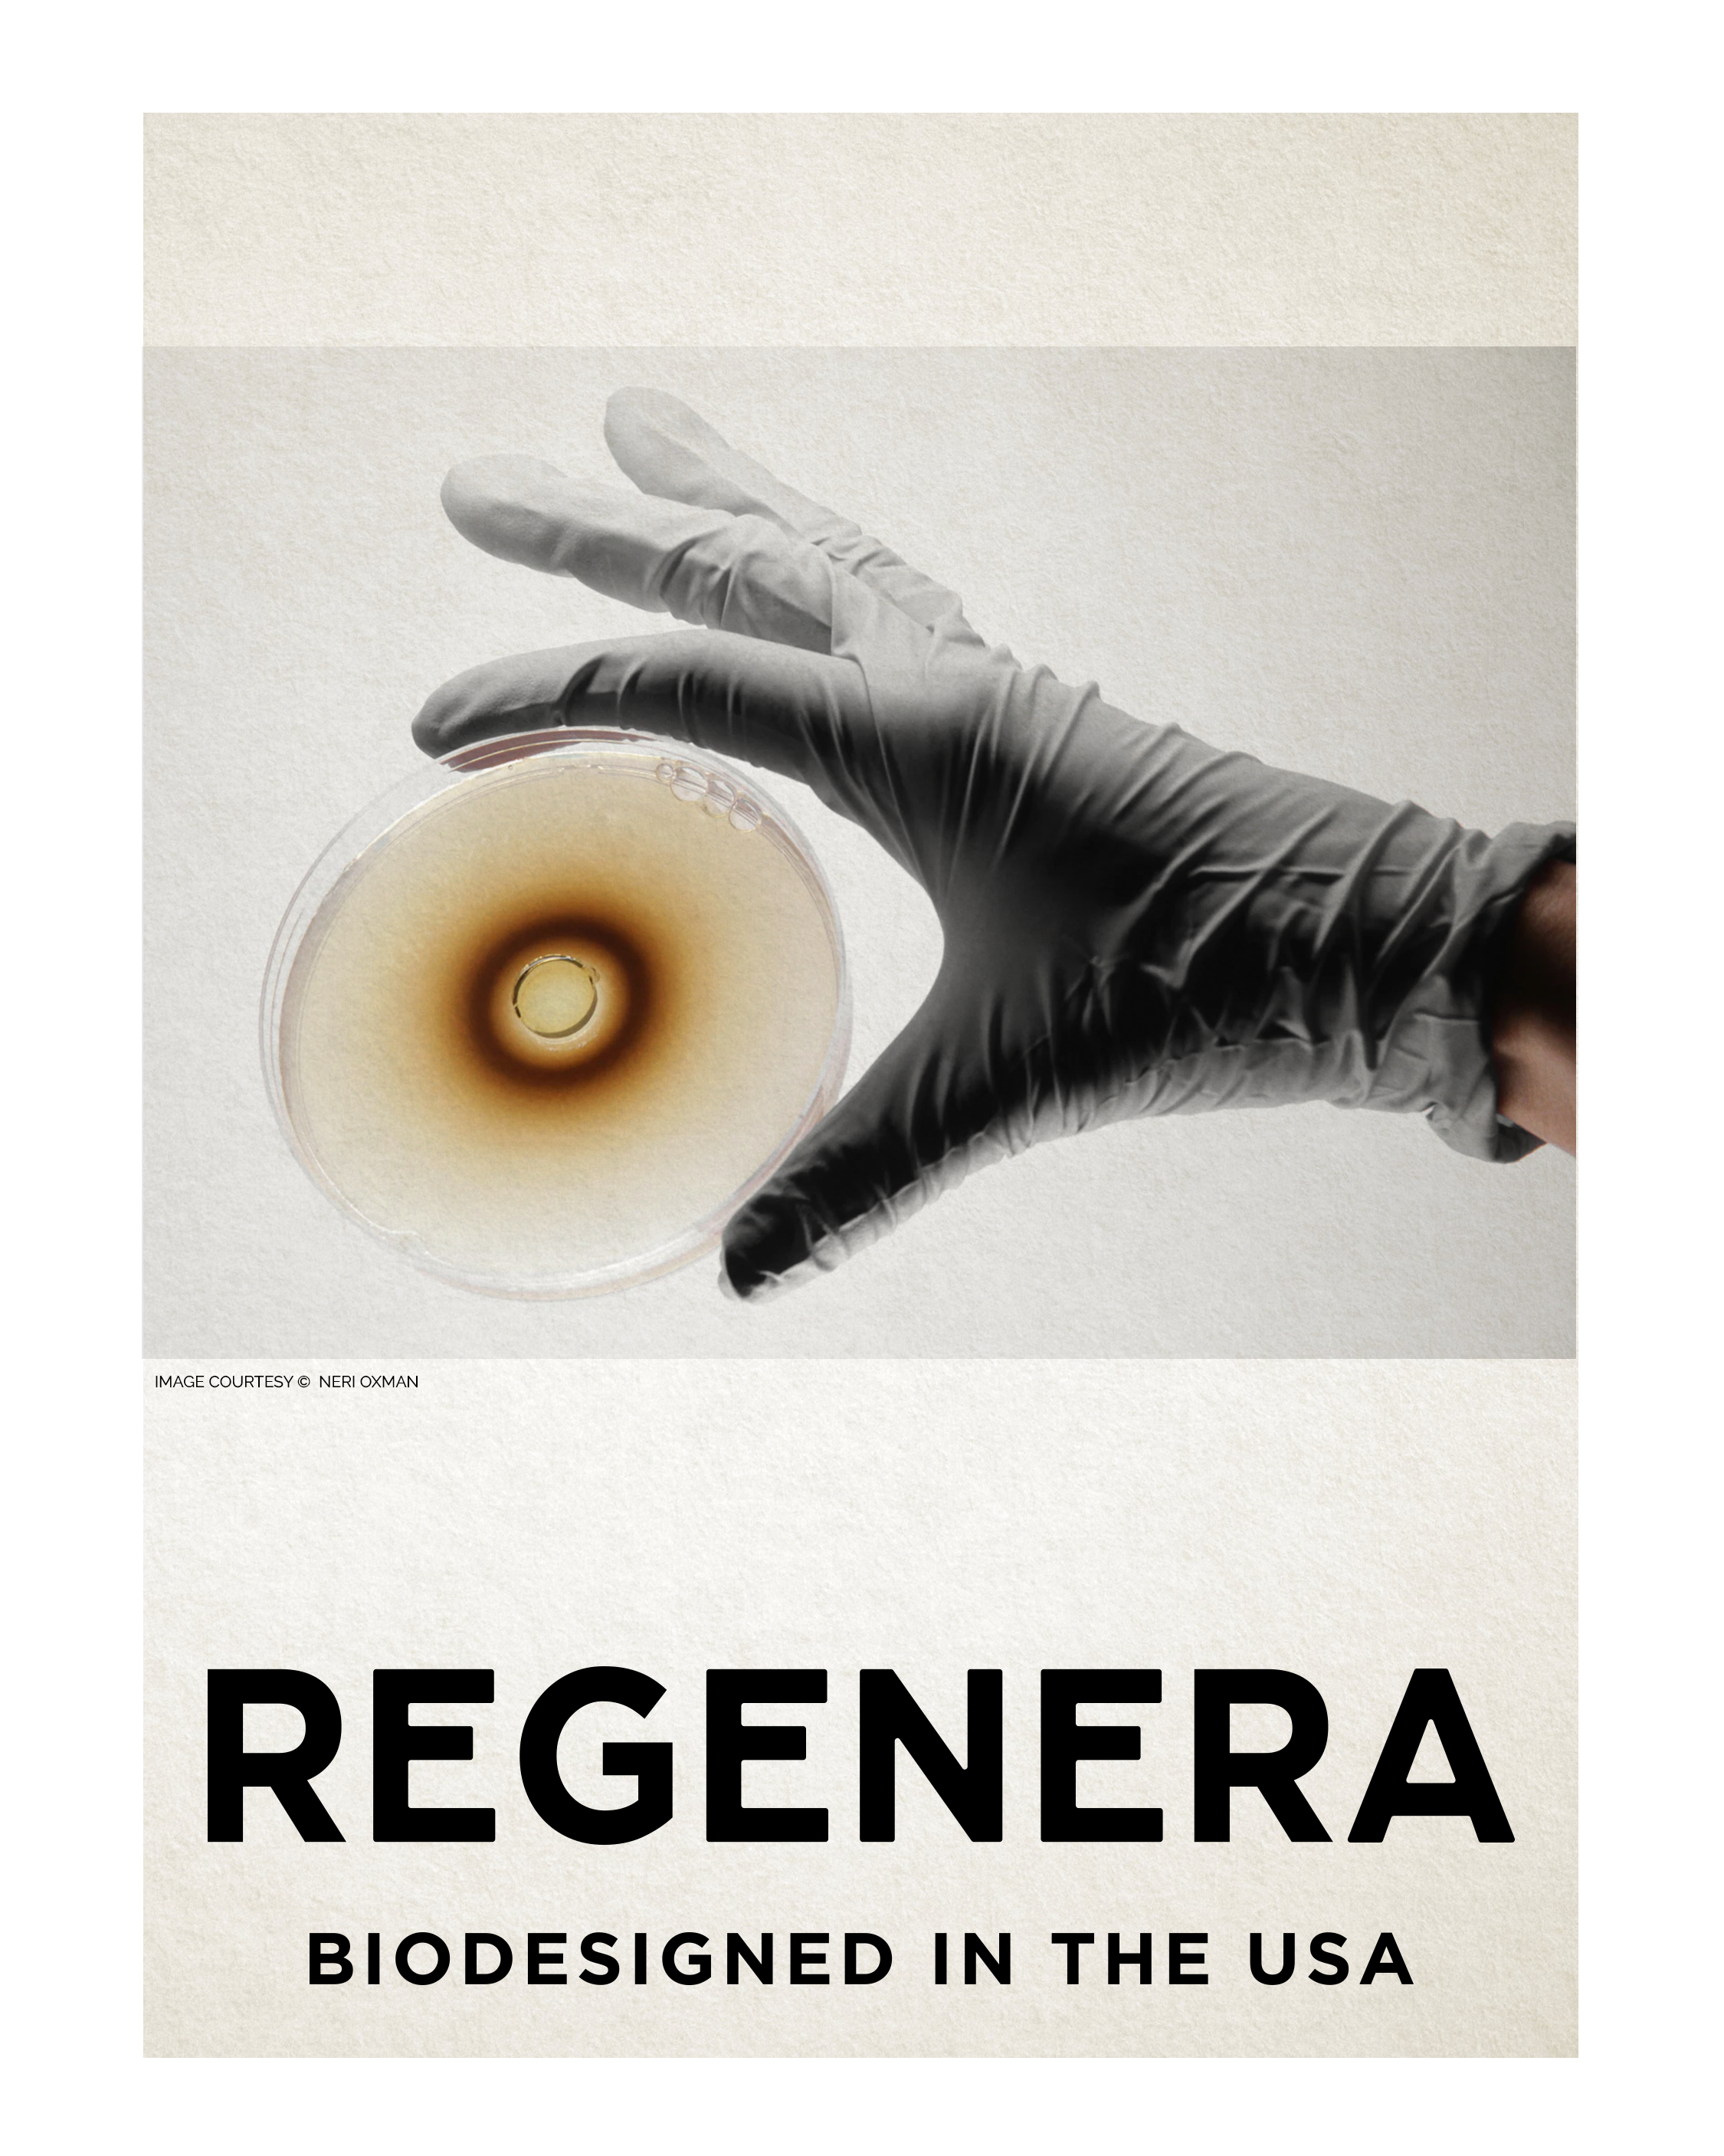

INSPIRATION
Regenera draws its inspiration from art, culture, science, architecture and tech discoveries. Powerfull souvenirs of human being's ingenuosity that the founders took back with them from their travels.

ART
At RegenEra, we believe that your skin deserves the best in cutting-edge technology and natural renewal. Our products are more than just skincare; they are the embodiment of longevity, infinity, and regeneration, designed to bring out the best in your skin for years to come.

ARCHITECTURE
Use this text to share information about your brand with your customers. Describe a product, share announcements, or welcome customers to your store.

DESIGN, FASHION AND MATERIALITY
Use this text to share information about your brand with your customers. Describe a product, share announcements, or welcome customers to your store.
SCIENCE & TECHNOLOGY
Use this text to share information about your brand with your customers. Describe a product, share announcements, or welcome customers to your store.